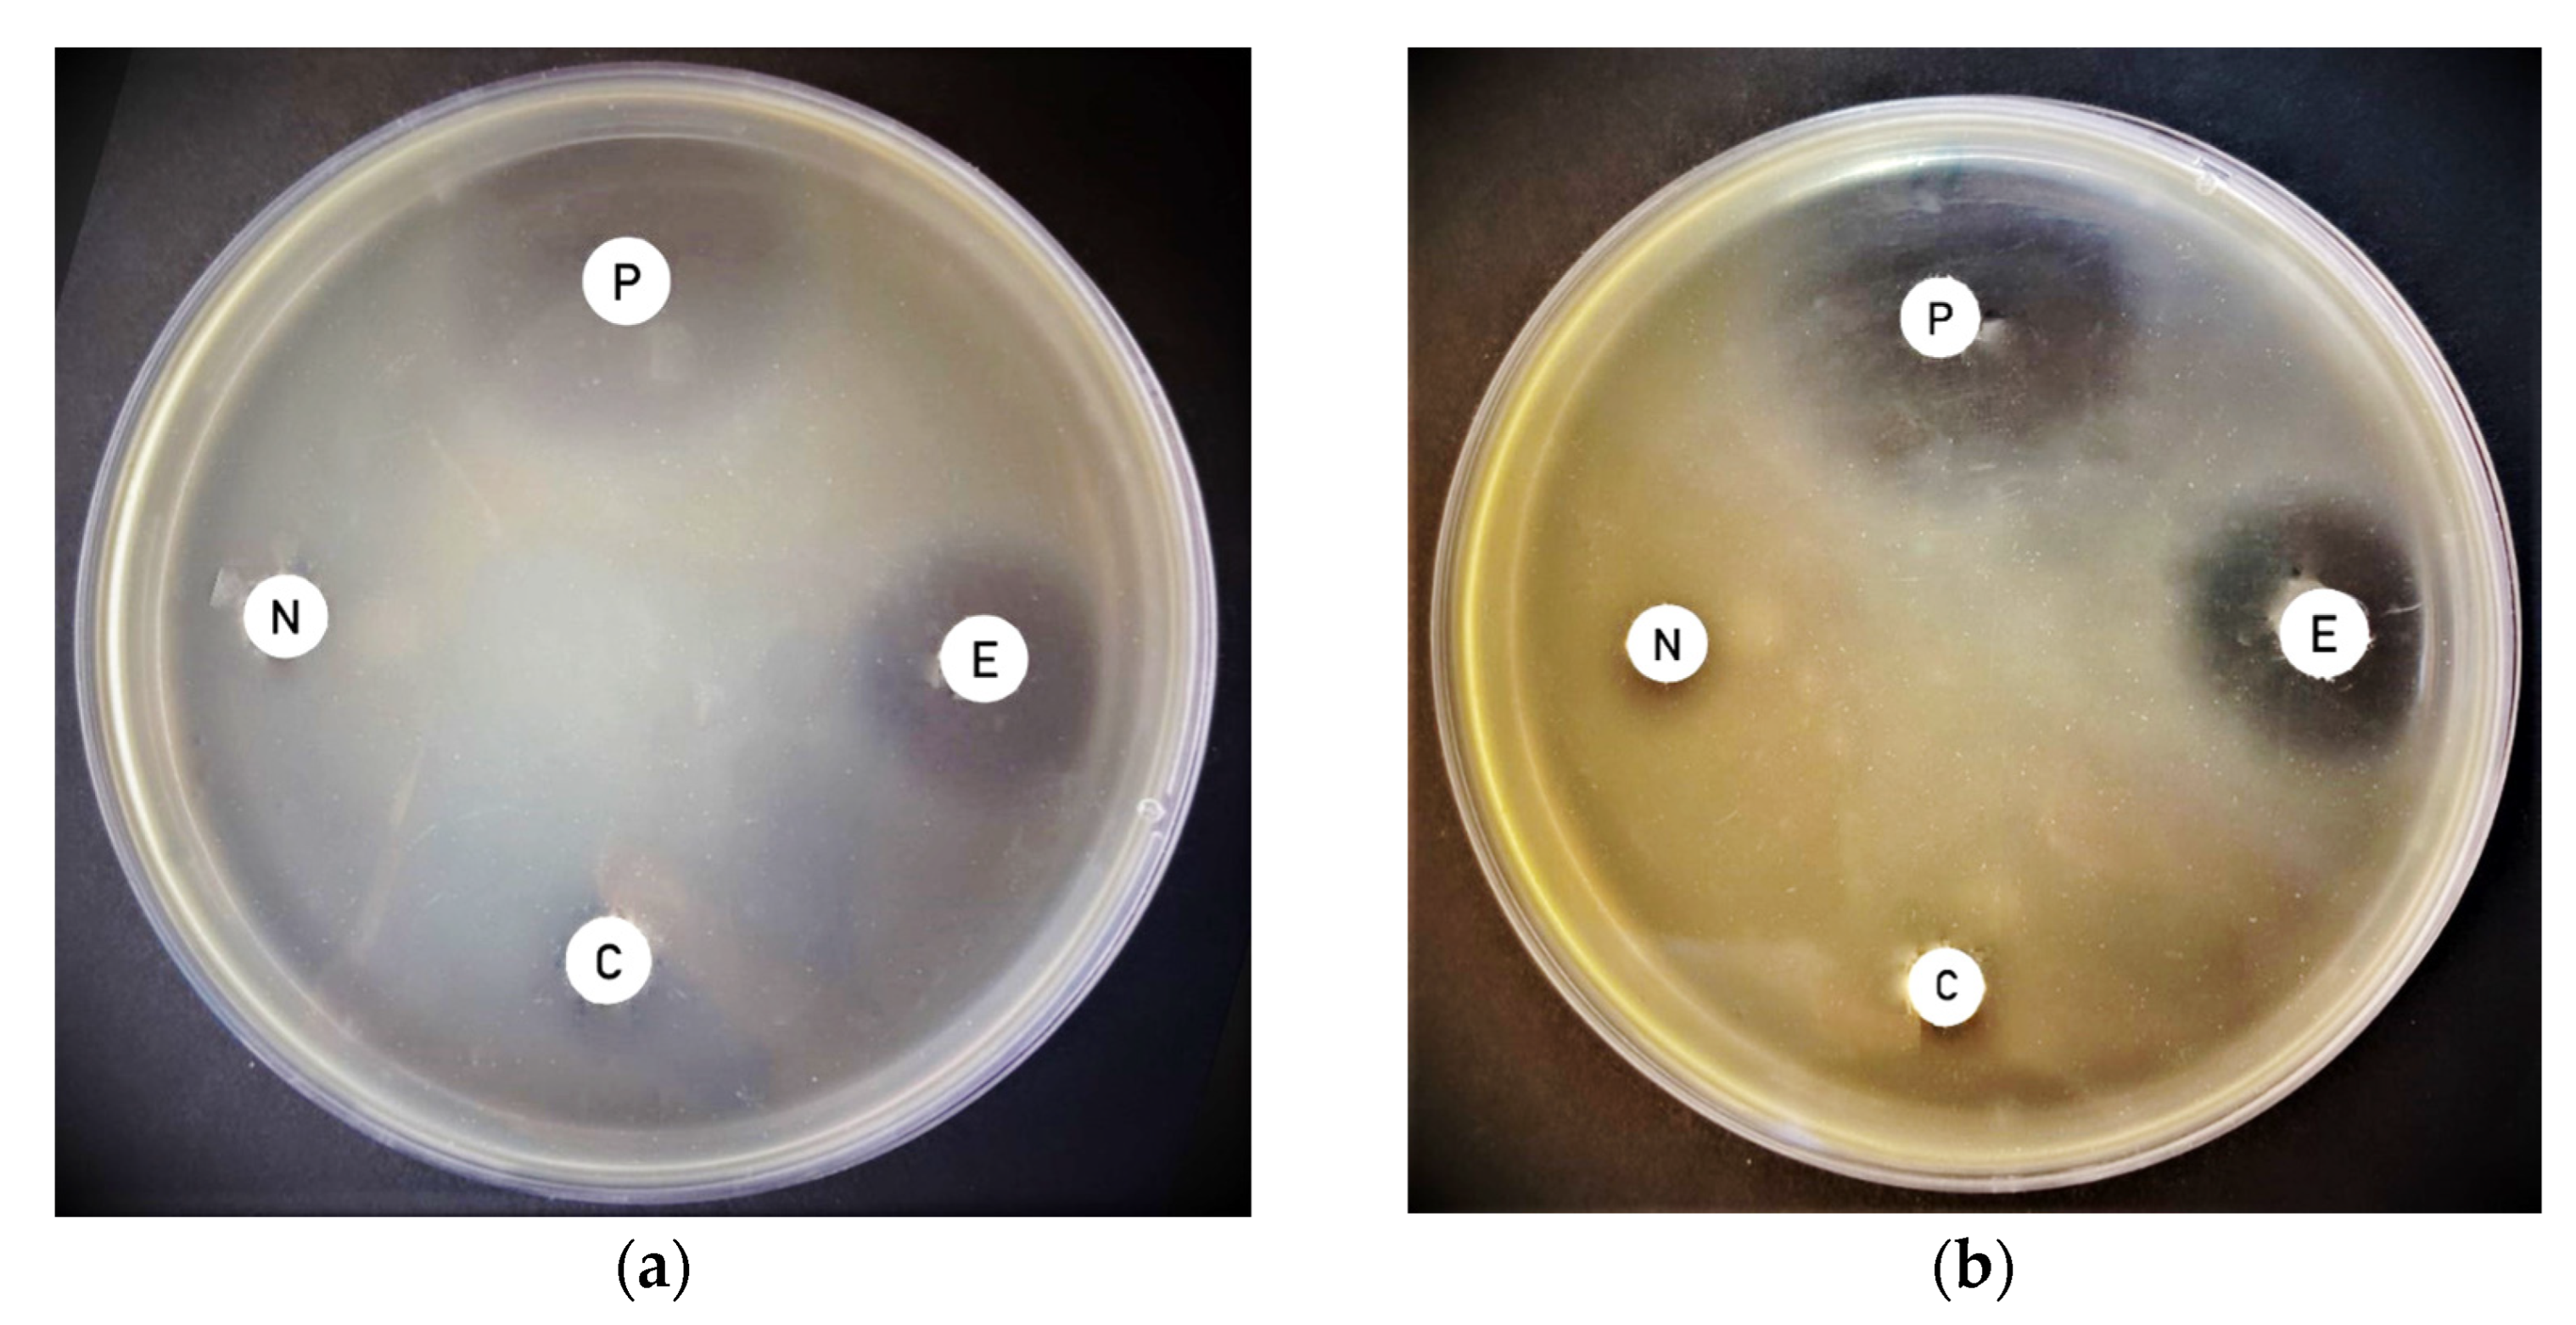
Applsci 12 04933 g003 550

A Novel Application of Laser in Biocontrol of Plant Pathogenic Bacteria
Abstract: Background
1. Background
2. Methods
2.1. Isolation of Tomato Pathogenic Bacterium and Initial Detection via Gram Stain
2.2. Cyanobacterial Samples
2.3. DNA Extraction of Bacterial Colonies
2.4. PCR Amplification of DNA from Pathogenic Bacteria
- Initial denaturation at 94 °C for 2 min.
- Thirty cycles where in each cycle the following stages were run:
- 3.
- Final extension step at 72 °C for 10 min.
2.5. Cyanobacterial Biomass and Cyanobacterial Extract Preparation for Laser Treatment
- Cyanobacterial extract not exposed to laser (control).
- Cyanobacterial extract derived from biomass pre-exposed to laser radiation.
- Cyanobacterial extract directly exposed to laser radiation.
2.6. Antimicrobial Bioassay
2.7. Statistical Analysis Using Split Plot -ANOVA
3. Results
3.1. Characterization of the Plant Pathogenic Bacterial Strain Isolated from Tomato
3.2. Laser Treatments
3.3. Effect of Laser Treatment on Antimicrobial Activity of Thermoleptolyngbya sp. Biomass Pre-Exposed to Laser and Directly Exposed Extracts against Pantoea vagnas
3.4. Effect of Laser Treatment on Antimicrobial Activity of Leptolyngbya sp. Biomass Pre-Exposed to Laser and Extracts Directly Exposed against Pantoea vagnas
3.5. Effect of Laser Treatment on Antimicrobial Activity of Synechococcus elongatus Biomass Pre-Exposed to Laser and Extracts Directly Exposed against Pantoea vagnas
4. Discussion
5. Conclusions
Author Contributions
Funding
Institutional Review Board Statement
Informed Consent Statement
Data Availability Statement
Acknowledgments
Conflicts of Interest
References
- El Semary, N.A. The polyphasic description of a Phormidium-like cyanobacterium from Egypt with antimicrobial activity of its methanolic extract. Nova Hedwig. Ger. 2011, 92, 377–390. [Google Scholar] [CrossRef]
- El Semary, N.A. The characterisation of bioactive compounds from an Egyptian Leptolyngbya sp. strain. Ann. Microbiol. 2012, 62, 55–59. [Google Scholar] [CrossRef]
- El Semary, N.A. The antimicrobial profile of extracts of a Phormidium-like cyanobacterium changes with phosphate levels. World J. Microbiol. Biotechnol. 2012, 28, 585–593. [Google Scholar] [CrossRef] [PubMed]
- Mandal, S.; Rath, J. Secondary metabolites of cyanobacteria and drug development. In Extremophilic Cyanobacteria for Novel Drug Development; Springer: Berlin, Germany, 2015; pp. 23–43. [Google Scholar]
- Ehrenreich, I.M.; Waterbury, J.B.; Webb, E.A. Distribution and diversity of natural product genes in marine and freshwater cyanobacterial cultures and genomes. Appl. Environ. Microbiol. 2005, 71, 7401–7413. [Google Scholar] [CrossRef] [Green Version]
- Borowitzka, M.A. Microalgae as sources of pharmaceuticals and other biologically active compounds. J. Appl. Phycol. 1995, 7, 3–15. [Google Scholar] [CrossRef]
- El-Sheekh, M.M.; Osman, M.E.; Dyab, M.A.; Amer, M.S. Production and characterization of antimicrobial active substance from the cyanobacterium nostoc muscorum. Environ. Toxicol. Pharmacol. 2006, 21, 42–50. [Google Scholar] [CrossRef]
- Gupta, V.; Ratha, S.K.; Sood, A.; Chaudhary, V.; Prasanna, R. New insights into the biodiversity and applications of cyanobacteria (blue-green algae)—Prospects and challenges. Algal Res. 2013, 2, 79–97. [Google Scholar] [CrossRef]
- Noaman, N.H.; Fattah, A.; Khaleafa, M.; Zaky, S.H. Factors affecting antimicrobial activity of Synechococcus leopoliensis. Microbiol. Res. 2004, 159, 395–402. [Google Scholar] [CrossRef]
- Thummajitsakul, S.; Silprasit, K.; Sittipraneed, S. Antibacterial activity of crude extracts of Cyanobacteria Phormidium and Microcoleus species. Afr. J. Microbiol. Res. 2012, 6, 2574–2579. [Google Scholar] [CrossRef]
- Abd El-Aty, A.M.; Mohamed, A.A.; Samhan, F.A. In vitro antioxidant and antibacterial activities of two fresh water cyanobacterial species, Oscillatoria agardhii and Anabaena sphaerica. J. Appl. Pharm. Sci. 2014, 4, 69. [Google Scholar]
- Ozdemir, G.; Ulku Karabay, N.; Dalay, M.C.; Pazarbasi, B. Antibacterial activity of volatile component and various extracts of Spirulina platensis. Phytother. Res. Int. J. Devoted Pharmacol. Toxicol. Eval. Nat. Prod. Deriv. 2004, 18, 754–757. [Google Scholar]
- Shaieb, F.A.; Issa, A.A.; Meragaa, A. Antimicrobial activity of crude extracts of Cyanobacteria nostoc commune and spirulina platensis. Arch. Biomed. Sci. 2014, 2, 34–41. [Google Scholar]
- Del Pilar Sánchez-Saavedra, M.; Licea-Navarro, A.; Bernáldez-Sarabia, J. Evaluation of the antibacterial activity of different species of phytoplankton. Rev. Biol. Mar. Oceanogr. 2010, 45, 531–536. [Google Scholar] [CrossRef]
- El Semary, N.A.; Osman, M.E.; Ahmed, A.S.; Botros, H.W.; Farag, A.T. Antibiosis towards human and plant pathogens via radiation-induced Synechococcus elongatus. Egypt. J. Biol. Pest Control 2015, 25, 393–399. [Google Scholar]
- Al Dayel, M.; El Semary, N.A. UV irradiation promoting effect on the antibacterial activity of cyanobacterial extracts against plant pathogens: A first record. Egyptian J. Biol. Pest Control. 2020, 30, 132. [Google Scholar] [CrossRef]
- Najeeb, S.; Khurshid, Z.; Zafar, M.S.; Ajlal, S. Applications of light amplification by stimulated emission of radiation (LASERs) for restorative dentistry. Med. Princ. Pract. 2016, 25, 201–211. [Google Scholar] [CrossRef]
- Rethfeld, B.; Ivanov, D.S.; Garcia, M.E.; Anisimov, S.I. Modelling ultrafast LASER ablation. J. Phys. D Appl. Phys. 2017, 50, 193001. [Google Scholar] [CrossRef]
- Bjordal, J.M.; Couppé, C.; Chow, R.T.; Tunér, J.; Ljunggren, E.A. A systematic review of low level LASER therapy with location-specific doses for pain from chronic joint disorders. Aust. J. Physiother. 2003, 49, 107–116. [Google Scholar] [CrossRef] [Green Version]
- Oron, U.; Yaakobi, T.; Oron, A.; Mordechovitz, D.; Shofti, R.; Hayam, G.; Dror, U.; Gepstein, L.; Wolf, T.; Haudenschild, C.; et al. Low-Energy Laser Irradiation Reduces Formation of Scar Tissue After Myocardial Infarction in Rats and Dogs. Circulation 2001, 103, 296–301. [Google Scholar] [CrossRef] [Green Version]
- Sommer, A.P.; Pinheiro, A.L.; Mester, A.R.; Franke, R.-P.; Whelan, H.T. Biostimulatory windows in low-intensity laser activation: Lasers, scanners, and nasa’s light-emitting diode array system. J. Clin. Laser Med. Surg. 2001, 19, 29–33. [Google Scholar] [CrossRef]
- Hu, W.P.; Wang, J.J.; Yu, C.L.; Lan CC, E.; Chen, G.S.; Yu, H.S. Helium–neon laser irradiation stimulates cell proliferation through photostimulatory effects in mitochondria. J. Investig. Dermatol. 2007, 127, 2048–2057. [Google Scholar] [CrossRef] [Green Version]
- Belykh, E.; Yagmurlu, K.; Martirosyan, N.L.; Lei, T.; Izadyyazdanabadi, M.; Malik, K.M.; Byvaltsev, V.A.; Nakaji, P.; Preul, M.C. Laser application in neurosurgery. Surg. Neurol. Int. 2017, 8, 274. [Google Scholar] [PubMed]
- Kolari, P.; Airaksinen, O. Penetration of infra-red and helium-neon LASER light into the tissue. Acupunct. Electro Ther. Res. J. 1988, 13, 232–233. [Google Scholar]
- Nykyforov, V.; Maznytska, O.; Novokhatko, O.; Pasenko, A.; Malovanyy, M.; Tymchuk, I. LAER pretreating of cyanobacteria biomass to produce lipids as a renewable energy source. Environ. Eng. Manag. J. 2021, 20, 1255–1262. [Google Scholar]
- Claus, D. A standardized gram staining procedure. World J. Microbiol. Biotechnol. 1992, 8, 451–452. [Google Scholar] [CrossRef] [Green Version]
- Allen, M.M. Simple conditions for growth of unicellular blue-green algae on plates. J. Phycol. 1968, 4, 1–4. [Google Scholar] [CrossRef] [PubMed]
- Allen, M.M.; Stanier, R.Y. Selective isolation of blue-green algae from water and soil. Microbiology 1968, 51, 203–209. [Google Scholar] [CrossRef] [Green Version]
- Rippka, R.; Deruelles, J.; Waterbury, J.B.; Herdman, M.; Stanier, R.Y. Generic assignments, strain histories and properties of pure cultures of Cyanobacteria. Microbiology 1979, 111, 1–61. [Google Scholar] [CrossRef] [Green Version]
- Junior, J.C.R.; Tamanini, R.; Soares, B.F.; de Oliveira, A.M.; de Godoi Silva, F.; da Silva, F.F.; Augusto, N.A.; Beloti, V. Efficiency of boiling and four other methods for genomic DNA extraction of deteriorating spore-forming bacteria from milk. Semin. Ciências Agrárias 2016, 37, 3069–3078. [Google Scholar] [CrossRef]
- Bauer, A.W. Antibiotic susceptibility testing by a standardized single disc method. Am. J. Clin. Pathol. 1966, 45, 149–158. [Google Scholar] [CrossRef]
- Al Dayel, M.; El Semary, N.; Al Amer, K.; Al Ali, K. Investigating the applications of Chlorella vulgaris in agriculture and nanosilver production. J. Environ. Biol. 2020, 41, 1099–1104. [Google Scholar] [CrossRef]
- Heidari, F.; Riahi, H.; Yousefzadi, M.; Asadi, M. Antimicrobial activity of Cyanobacteria isolated from hot spring of geno. Middle-East J. Sci. Res. 2012, 12, 336–339. [Google Scholar]
- Gerez-Martel, I.; García-Poza, S.; Rodríguez-Martel, G.; Rico, M.; Afonso-Olivares, C.; Gómez-Pinchetti, J.L. Phenolic profile and antioxidant activity of crude extracts from microalgae and Cyanobacteria strains. J. Food Qual. 2017, 2017, 2924508. [Google Scholar] [CrossRef] [Green Version]
- Monserrat, J.M.; Yunes, J.S.; Bianchini, A. Effects of Anabaena spiroides (Cyanobacteria) aqueous extracts on the acetylcholinesterase activity of aquatic species. Environ. Toxicol. Chem. Int. J. 2001, 20, 1228–1235. [Google Scholar] [CrossRef]
- Sonani, R.R.; Rastogi, R.P.; Patel, R.; Madamwar, D. Recent advances in production, purification and applications of phycobiliproteins. World J. Biol. Chem. 2016, 7, 100. [Google Scholar] [CrossRef]
- Najdenski, H.M.; Gigova, L.G.; Iliev, I.I.; Pilarski, P.S.; Lukavský, J.; Tsvetkova, I.V.; Ninova, M.S.; Kussovski, V.K. Antibacterial and antifungal activities of selected microalgae and Cyanobacteria. Int. J. Food Sci. Technol. 2013, 48, 1533–1540. [Google Scholar] [CrossRef]
- Sabarinathan, K.; Ganesan, G. Antibacterial and toxicity evaluation of C-phycocyanin and cell extract of filamentous freshwater cyanobacterium–. Eur. Rev. Med. Pharmacol. Sci. 2008, 12, 79–82. [Google Scholar]
- Afreen, S.; Fatma, T. Extraction, purification and characterization of phycoerythrin from Michrochaete and its biological activities. Biocatal. Agric. Biotechnol. 2018, 13, 84–89. [Google Scholar]
- Kim, N.N.; Shin, H.S.; Park, H.G.; Lee, J.; Kil, G.S.; Choi, C.Y. Profiles of photosynthetic pigment accumulation and expression of photosynthesis-related genes in the marine cyanobacteria Synechococcus sp.: Effects of LED wavelengths. Biotechnol. Bioprocess Eng. 2014, 19, 250–256. [Google Scholar] [CrossRef]
- Li, W.T.; Leu, Y.C.; Wu, J.L. Red-light light-emitting diode irradiation increases the proliferation and osteogenic differentiation of rat bone marrow mesenchymal stem cells. Photomed. LASER Surg. 2010, 28, S-157. [Google Scholar] [CrossRef]
- Chen, H.W.; Yang, T.S.; Chen, M.J.; Chang, Y.C.; Wang, E.I.C.; Ho, C.L.; Lai, Y.J.; Yu, C.C.; Chou, J.C.; Chao, L.K.P.; et al. Purification and immunomodulating activity of C-phycocyanin from Spirulina platensis cultured using power plant flue gas. Process Biochem. 2014, 49, 1337–1344. [Google Scholar] [CrossRef] [Green Version]
- Sivasankari, S.; Vinoth, M.; Ravindran, D.; Baskar, K.; Alqarawi, A.A.; Abd_Allah, E.F. Efficacy of red light for enhanced cell disruption and fluorescence intensity of phycocyanin. Bioprocess Biosyst. Eng. 2021, 44, 141–150. [Google Scholar] [CrossRef]
- Sugita, C.; Ogata, K.; Shikata, M.; Jikuya, H.; Takano, J.; Furumichi, M.; Kanehisa, M.; Omata, T.; Sugiura, M.; Sugita, M. Complete nucleotide sequence of the freshwater unicellular cyanobacterium Synechococcus elongatus PCC 6301 chromosome: Gene content and organization. Photosynth. Res. 2007, 93, 55–67. [Google Scholar] [CrossRef]
- Tan, L.R.; Xia, P.F.; Sun, X.F.; Guo, N.; Song, C.; Li, Q.; Wang, S.G. Ecological insights into low-level antibiotics interfered biofilms of Synechococcus elongatus. RSC Adv. 2016, 6, 78132–78135. [Google Scholar] [CrossRef]
- Martins, R.F.; Ramos, M.F.; Herfindal, L.; Sousa, J.A.; Skærven, K.; Vasconcelos, V.M. Antimicrobial and cytotoxic assessment of marine Cyanobacteria-Synechocystis and Synechococcus. Mar. Drugs 2008, 6, 1–11. [Google Scholar] [CrossRef]
- Strieth, D.; Lenz, S.; Ulber, R. In vivo and in silico screening for antimicrobial compounds from cyanobacteria. MicrobiologyOpen 2022, 11, e1268. [Google Scholar] [CrossRef]
- Konstantinou, D.; Mavrogonatou, E.; Zervou, S.K.; Giannogonas, P.; Gkelis, S. Bioprospecting sponge-associated marine cyanobacteria to produce bioactive compounds. Toxins 2020, 12, 73. [Google Scholar] [CrossRef]
- Conter, A.; Dupouy, D.; Delteil, C.; Planel, H. Influence of very low doses of ionizing radiation on Synechococcus lividus metabolism during the initial growth phase. Arch. Microbiol. 1986, 144, 286–290. [Google Scholar] [CrossRef]
- Xue, L.; Li, S.; Sheng, H.; Feng, H.; Xu, S.; An, L. Nitric oxide alleviates oxidative damage induced by enhanced ultraviolet-B radiation in cyanobacterium. Curr. Microbiol. 2007, 55, 294–301. [Google Scholar] [CrossRef]
- Rastogi, R.P.; Sinha, R.P.; Moh, S.H.; Lee, T.K.; Kottuparambil, S.; Kim, Y.J.; Rhee, J.S.; Choi, E.M.; Brown, M.T.; Häder, D.P.; et al. Ultraviolet radiation and cyanobacteria. J. Photochem. Photobiol. B Biol. 2014, 141, 154–169. [Google Scholar] [CrossRef] [Green Version]

| Cyanobacterial Strain | Distance | Exposure Time | Pantoea vagans Inhibition Zone (mm) Extract from Biomass Pre-Exposed to Laser | Pantoea vagans Inhibition Zone (mm) Extract Directly Exposed to Laser |
|---|---|---|---|---|
| Thermoleptolyngbya sp. | 5 cm | 4 min | 8.5 ± 2.1 | Nil |
| 16 min | 9.5 ± 3.5 | 8.5 ± 2.1 | ||
| 32 min | 7.0 ± 0.0 | Nil ± 0 | ||
| 10 cm | 4 min | 9.0 ± 1.4 | 15.0 ± 0.7 * | |
| 16 min | 8.0 ± 0.0 | 11.5 ± 2.1 | ||
| 32 min | 9.0 ± 1.4 | 15.0 ± 4.2 * | ||
| Control | - | - | 9.5 ± 0.7 | 9.5 ± 0.7 |
| Leptolyngbya sp. | 5 cm | 4 min | 7.5 ± 0.7 | 10.0 ± 0.0 |
| 16 min | 8.0 ± 1.4 | 11.0 ± 1.4 | ||
| 32 min | 9.5 ± 0.7 | 13.0 ± 0.0 | ||
| 10 cm | 4 min | 9.0 ± 1.4 | Nil | |
| 16 min | 10.5 ± 2.1 | Nil | ||
| 32 min | 12.0 ± 0.0 | 14.0 ± 4.2 | ||
| Control | - | - | 11 ± 1.7 | 11 ± 1.7 |
| Synechcococcus elongatus | 5 cm | 4 min | 8.5 ± 2.1 | 14.0 ± 4.2 * |
| 16 min | 9.0 ± 1.4 | Nil | ||
| 32 min | 10.0 ± 2.8 | 13.0 ± 0.0 * | ||
| 10 cm | 4 min | 9.0 ± 0.7 | 15.5 ± 3.5 ** | |
| 16 min | 12.5 ± 3.5 * | 15.0 ± 2.8 * | ||
| 32 min | 10.0 ± 0.0 | 14.5 ± 3.5 * | ||
| Control | - | - | 7.5 ± 0.7 | 7.5 ± 0.7 |
Publisher’s Note: MDPI stays neutral with regard to jurisdictional claims in published maps and institutional affiliations. |
© 2022 by the authors. Licensee MDPI, Basel, Switzerland. This article is an open access article distributed under the terms and conditions of the Creative Commons Attribution (CC BY) license (https://creativecommons.org/licenses/by/4.0/).
Share and Cite
El Semary, N.; Al Naim, H.; Aldayel, M.F. A Novel Application of Laser in Biocontrol of Plant Pathogenic Bacteria. Appl. Sci. 2022, 12, 4933. https://doi.org/10.3390/app12104933
El Semary N, Al Naim H, Aldayel MF. A Novel Application of Laser in Biocontrol of Plant Pathogenic Bacteria. Applied Sciences. 2022; 12(10):4933. https://doi.org/10.3390/app12104933
Chicago/Turabian StyleEl Semary, Nermin, Haifa Al Naim, and Munirah F. Aldayel. 2022. "A Novel Application of Laser in Biocontrol of Plant Pathogenic Bacteria" Applied Sciences 12, no. 10: 4933. https://doi.org/10.3390/app12104933
APA StyleEl Semary, N., Al Naim, H., & Aldayel, M. F. (2022). A Novel Application of Laser in Biocontrol of Plant Pathogenic Bacteria. Applied Sciences, 12(10), 4933. https://doi.org/10.3390/app12104933






